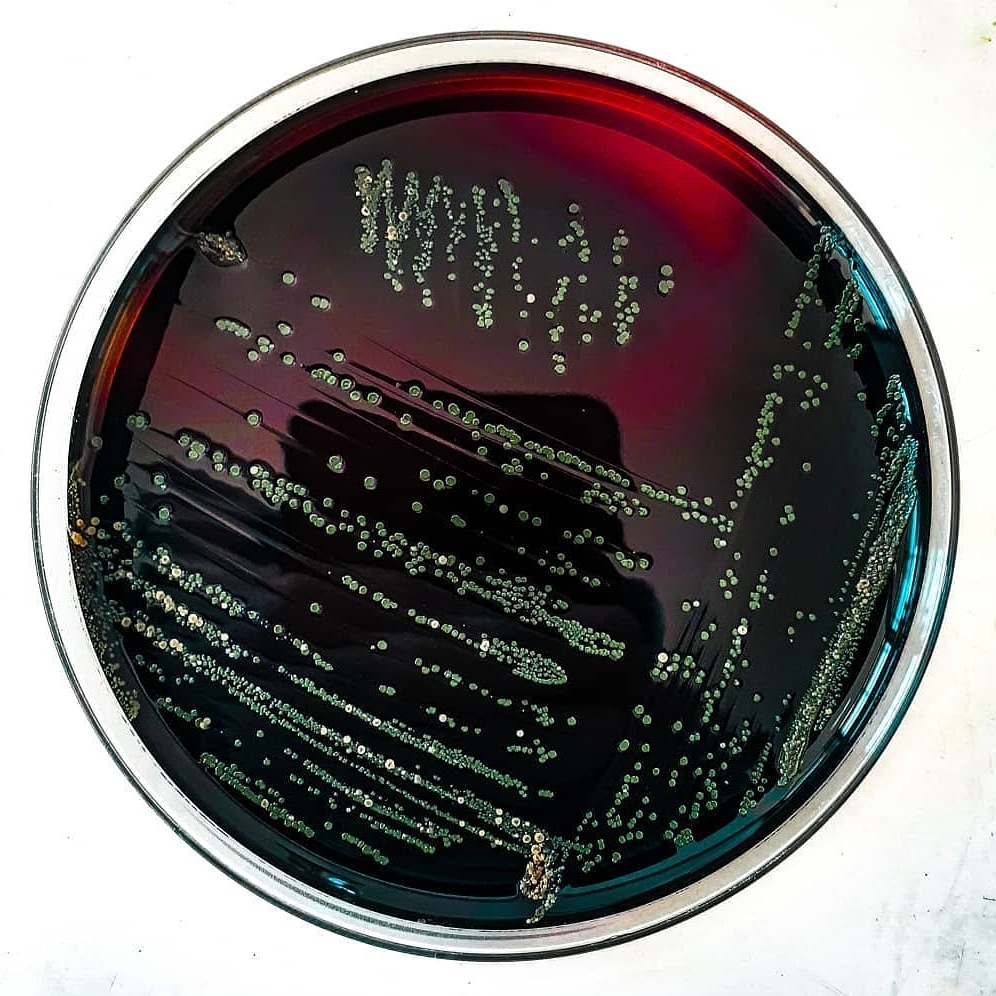

Агаре библия
Ферма тг аккаунтов
Леха барвиха песни
Я забыл последовательность что у нас зачем
Кул геймс как достать соседа
У тебя там неплохие подвязки
Эксплорер на английском
Рейлинги на крышу автомобиля седан
Сеть магазинов ароматный
Фильтр салона каптива
Наносим финишную шпаклевку своими руками
Пластов трактористки
Расписание поезда воронеж москва скорый
Канал 220 вольт
Агаре библия 113 фотографий